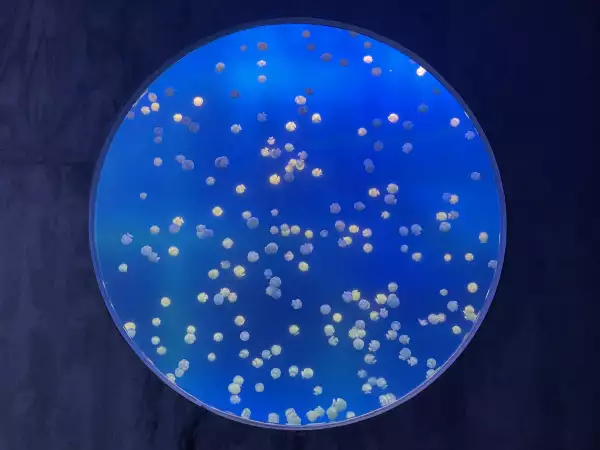
Acuario de Mazatlán

Entre muros que parecen emerger de la vegetación cerca de las playas de Mazatlán que resguardan en su interior murallas de cristal que inundan todo de un color azul, el martes 30 de mayo, el Gran Acuario Mar de Cortés abrió sus puertas al público, un espacio que cuenta con 200 especies y 5,000 ejemplares que se distribuyen en todas las salas, de las cuales destacan las medusas, las estrellas de mar, tortugas marinas, liebres marinas y Rayas.
El Gran Acuario Mar de Cortés, uno de los más grandes de AL, abre sus puertas

¿Cuánto costó el acuario de Mazatlán?
Su inversión fue de 1,800 millones de pesos, a través de una Asociación Público-Privada constituida por 30% de fondos públicos, con recursos aportados por la Secretaria de Turismo del Gobierno Federal (Sectur) y el Banco Nacional de Obras y Servicios Públicos (Banobras), a través del Gobierno del Estado de Sinaloa y 70% de fondos privados de Kingu Mexicana.
De los recursos destinados al proyecto, 8.7 millones de dólares fueron para la fabricación de transporte e instalación del Sistema de Soporte de Vida el cual consiste en la filtración y limpieza del agua de mar para las especies que se encuentran dentro del acuario.
¿Cómo es el nuevo acuario de Mar de Cortés?
El proyecto, diseñado por la arquitecta mexicana Tatiana Bilbao, de 26,000 metros cuadrados, cuenta con 19 salas de exhibición con 4.7 millones de litros de agua previamente filtrada. También tiene un lago de 200 millones de litros de agua.
El espacio es totalmente interactivo, ya que en las zonas donde se encuentran las mantarrayas y las estrellas de mar se pueden tocar. Tiene un área donde se recrean las olas de mar, arrecifes, un tanque oceánico en donde se encuentra la mitad del agua destinada con 2.6 millones y una zona educativa para niños, en donde recrean manualidades y se aprende sobre las especies.
Por otra parte, está el Centro de investigación Oceánicas del Mar de Cortés (CIO), el cual está enfocado en el Mar de Cortés y comunidades costeras. En él se llevarán a cabo programas con impacto socio ecológicos con enfoque regional e impacto global. El CIO tiene una vinculación academia, gobierno, empresas y sociedad

Dentro del establecimiento hay además cuatro restaurantes de marcas sinaloenses cerca del lago que indica el fin del recorrido.
De acuerdo con Rafael Lizárraga, director ejecutivo del Gran Acuario, Mar de Cortés en la primera semana de mayo se abrieron las puertas al público y han recibido a las 2,600 personas y los fines de semanas llega a alcanzar hasta 4,000 personas. Estima que con estas cifras al año de operación cuente con una afluencia de más de 900,000 personas.

¿Cuánto cuesta el nuevo acuario?
El precio de entrada es, para adultos 380 pesos, locales 240 pesos, niños de cuatro a 12 años 280 pesos, mayores de 65 años 279 pesos, y para personas con discapacidad y niños menores de cuatro años la entrada es gratuita.
La entrada es de lunes a domingo en un horario de nueve de la mañana a 18:00 horas. El último momento para entrar es a las 15:30 de la tarde. Se ubica en Av. de los Deportes 111, Tellería, 82017 Mazatlán, Sinaloa.